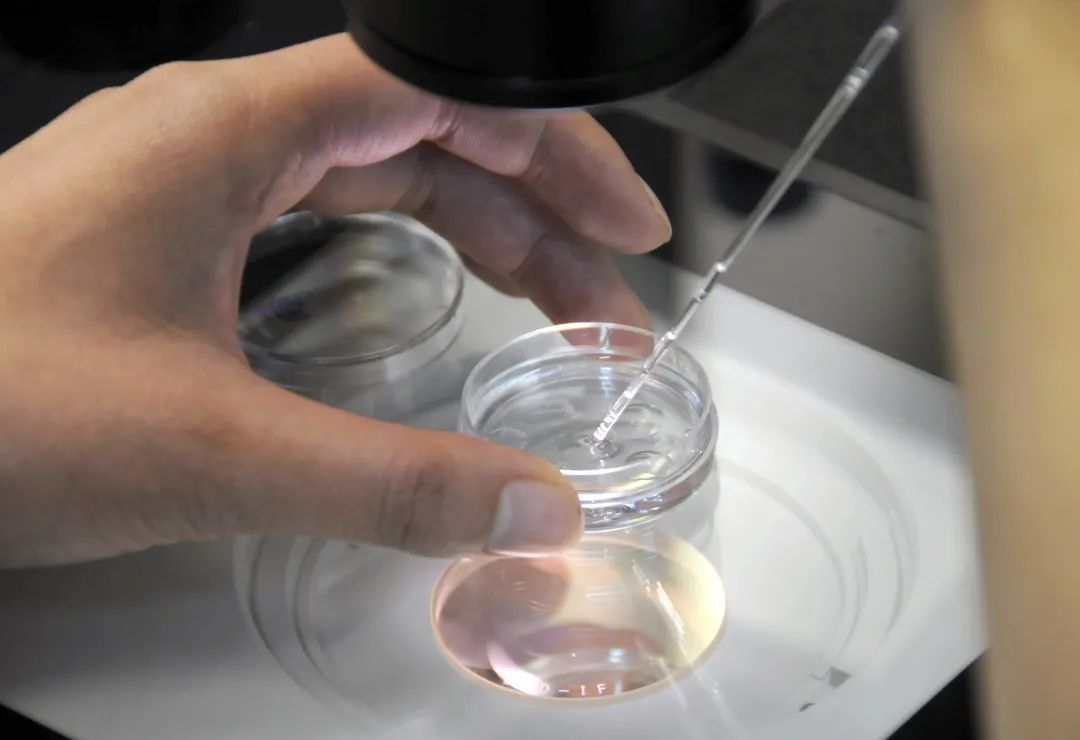

【生殖科普】“人工授精”与“试管婴儿”有什么不同?
人工授精和试管婴儿最大的区别是人工授精在输卵管内受精,是在体内受精,而试管婴儿在体外受精。

人工授精和试管婴儿最大的区别是人工授精在输卵管内受精,是在体内受精,而试管婴儿在体外受精。人工授精是指采用非性交的方式将精子递送到女性生殖道中以达到使女子受孕目的的一种辅助生殖技术(ART)。简单的说就是将精液在体外处理、优选后,将是筛选出的精子注入女方体内,完成受精过程。
人工授精的适应症:
1.精液异常:轻度或中度少精症、弱精症、非严重畸形精子症、液化异常;
2.因宫颈粘液异常造成精子无法通过宫颈导致的不孕;
3.因性功能障碍或生殖道畸形造成的性交障碍;
4.排卵障碍(如PCOS)、子宫内膜异位症经单纯药物处理不受孕;
5.不明原因不孕;
6.免疫性不孕。

人工授精和试管婴儿最大的区别是人工授精在输卵管内受精,是在体内受精,而试管婴儿在体外受精。试管婴儿是指分别将卵子与精子取出后在体外结合,经过实验室人员的专业技术培养发育成早期胚胎,再将胚胎移植回母体子宫内发育成胎儿的技术。
试管婴儿的适应症:
1.女方各种因素导致的配子运输障碍;
2.排卵障碍;
3.子宫内膜异位症;
4.男方少、弱、畸精子症;
5.免疫性不孕与不明原因的不育。
编辑制作|党办 刘畅 安珊珊 胡爽 姜任龙
供稿科室|生殖分院 文|王洋
图文校对|周冲 贾甜甜 王敬然 包卉 孙欣
医院动态
查看更多- 全力打造营商环境最佳口碑省!... 2026-01-23
- 【安全生产】请查收安全生产小贴士(十二)——《医... 2026-06-15
- 【书香医院】星耀好书 全民共享——我院第二届读书... 2026-06-15
- 【培训招生】2026年产前筛查与产前诊断技术人员... 2026-06-15
信息公开
查看更多- 空气灌肠机的采购公告... 2026-06-04
- 全自动凝血分析仪的采购公告... 2026-06-04
- 锦州市妇婴医院(妇幼保健院)2026年预算公开文... 2026-01-28
- 辽宁省锦州市妇婴医院2024年度部门决算公开... 2025-08-19



